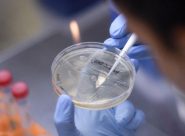

-

Elica, slitta al 19 ottobre
il tavolo al MiseFABRIANO – Comunicato questa mattina il posticipo per l’incontro inizialmente fissato in video-conferenza per domani. Il vertice è stato riconvocato in presenza. Ciccioli replica a Mangialardi e lo invita a votare in Consiglio regionale la sua mozione sulla vertenza
-

Strage Lanterna Azzurra,
richiesta rigettata:
il Comune non sarà parte civileIN AULA – Esclusa anche la Magic, società che gestiva la discoteca di Corinaldo. Udienza rinviata al 16 dicembre quando verranno formalizzate le richieste dei riti alternativi, preannunciati da 8 indagati su 19. Presente all’udienza il sindaco Matteo Principi: «L’unico obiettivo è la verità». Il papà di Emma Fabini: «Se tutti avessero svolto il loro lavoro mia figlia avrebbe compiuto oggi 17 anni»
-

Vertenza Elica, Mangialardi:
«Sbagliato parlare ora di esuberi»FABRIANO – Secondo il capogruppo del Pd regionale è possibile salvaguardare i livelli occupazionali e il documento che il consigliere di FdI Ciccioli porterà in discussione nel prossimo consiglio «è una misera paginetta di generici intenti»
-

Covid, 71 nuovi contagi
Un ricovero in meno negli ospedaliI DATI del Servizio sanità – Sono emersi dai 1.705 tamponi svolti nel percorso nuove diagnosi. Morto un 94enne di Ascoli
-

San Michele Arcangelo:
la polizia celebra il patronoANCONA – Durante la cerimonia il questore ha consegnato le medaglie di commiato al personale collocato in quiescenza e gli attestati di lode al personale che si è distinto in servizio
-
Covid, tamponi positivi in calo
Nelle Marche cinque mortiI DATI del Servizio sanità – Sono 61 i contagiati in regione (il 3% dei test svolti), 13 i casi nella provincia di Ancona
-

Cinzia Grucci presidente del Corecom
LA DIRIGENTE della Polizia Postale, prossima alla pensione, è stata nominata dal Consiglio regionale. Suo vice sarà il giornalista Maurizio Blasi
-

Crac Banca Marche,
assoluzione bis
per il collegio sindacaleIN AULA – Confermato in appello il verdetto emesso nel novembre del 2018 dal gup di Ancona per Franco D’Angelo, Marco Pierluca e Piero Valentini. Tra le accuse: bancarotta fraudolenta, falso in bilancio, falso in prospetto e ostacolo alla vigilanza. La procura aveva chiesto per ciascuno una condanna a 7 anni e 6 mesi
-

Tavolo al Mise per Elica,
lavoratori in sciopero
nel giorno del verticeFABRIANO – A sostegno della delegazione sindacale trattante Fim, Fiom e Uilm il 1 ottobre hanno proclamato 3 ore di stop al lavoro per ogni turno negli stabilimento di Mergo e Cerreto d’Esi
-

«Aborto libero, gratuito e farmacologico»
Presidio sotto Palazzo LeopardiANCONA – Sit-in questa mattina organizzato dall’associazione Non una di Meno Marche. «Denunciamo la campagna di disinformazione scientifica ed etica di cui si è resa protagonista l’attuale Giunta regionale, volta ad intimidire, influenzare, colpevolizzare le donne che vogliono interrompere la gravidanza»





